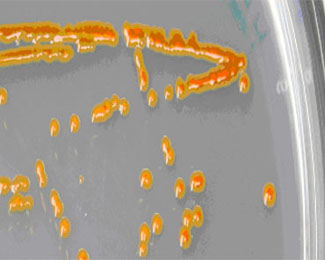
Colònies de Polaribacter sp.MED152 creixent en placa

- Home
Articles


Noroviruses hyperesistance
Acute gastroenteritis (AGE), often related to noroviruses, is one of the most common diseases suffered by the population. Noroviruses affect the stomach and intestines and are easily transmissible through human contact or in enclosed spaces, which would explain why they appear relatively frequently during...

Nanoscience: importance does not lie on nobility
The field of metallic nanoparticles (MNP), one of the nanoscience fields with most projection, advances daily. The exceptional characteristic physical and chemical properties of these particles make it possible to use them in electrochemical applications. However, this can...

More biodegradable organic wastes
The treatment of organic solid waste to obtain compost – which can be used as soil conditioner or fertilizer - is a complex process. However, certain physico-chemical and biological characteristics are required in a waste to be successfully composted. When...


Headlamp systems through the lens
Continuous innovation in headlamp systems also implies an improvement in how they are assessed. These assessment systems are based on dynamic comparison, i.e., experts or users themselves assess the quality of headlamps by means of different driving tests. The disadvantages of this...


Bacterial survival genes
A new advance in genomics research will allow for a better understanding of cellular and molecular life in oceans. In this case, the analysis focuses on the marine bacterium Polaribacter sp. MED152, a microorganism widely found in oceans which has survived in carbon-deficient environments and cannot always find...
Heavy metal accumulation in moss subjected to drought
Researchers at the Ecophysiology Unit of CSIC-CREAF have studied the possible negative effects of an increase in dryness would have in ecosystems of the Mediterranean Basin. Based on an experiment with adult holm oaks found in the Prades mountains in which the earth...

- 1
- 2
- 3
- 4
- 5
- 6
- 7
- 8
- 9
- 10
- 11
- 12
- 13
- 14
- 15
- 16
- 17
- 18
- 19
- 20
- 21
- 22
- 23
- 24
- 25
- 26
- 27
- 28
- 29
- 30
- 31
- 32
- 33
- 34
- 35
- 36
- 37
- 38
- 39
- 40
- 41
- 42
- 43
- 44
- 45
- 46
- 47
- 48
- 49
- 50
- 51
- 52
- 53
- 54
- 55
- 56
- 57
- 58
- 59
- 60
- 61
- 62
- 63
- 64
- 65
- 66
- 67
- 68
- 69
- 70
- 71
- 72
- 73
- 74
- 75
- 76
- 77
- 78
- 79
- 80
- 81
- 82
- 83
- 84
- 85
- 86
- 87
- 88
- 89
- 90
- 91
- 92
- 93
- 94
- 95
- 96
- 97
- 98
- 99
- 100
- 101
- 102
- 103
- 104
- 105
- 106
- 107
- 108
- 109
- 110
- 111
- 112
- 113
- 114
- 115
- 116
- 117
- 118
- 119
- 120
- 121
- 122
- 123
- 124
- 125
- 126
- 127
- 128
- 129
- 130
- 131
- 132
- 133
- 134
- 135
- 136
- 137
- 138
- 139
- 140
- 141
- 142
- 143
- 144
- 145
- 146
- 147
- 148
- 149
- 150
- 151
- 152
- 153
- 154
- 155
- 156
- 157
- 158
- 159
- 160
- 161
- 162
- 163
- 164
- 165
- 166
- 167
- 168
- 169
- 170
- 171
- 172
- 173
- 174
- 175
- 176
- 177
- 178
- 179
- 180
- 181
- 182
- 183
- 184
- 185
- 186
- 187
- 188
- 189
- 190
- 191
- 192
- 193
- 194
- 195
- 196
- 197
- 198
- 199
- 200
- 201
- 202
- 203
- 204
- 205
- 206
- 207
- 208
- 209
- 210
- 211

